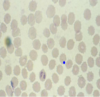

Copy of para midterm 1 Flashcards
(72 cards)
1
Q

A
Trypanosoma in blood
2
Q

A
Trypanosoma in blood
3
Q

A
Trypanosomosis (clinical sign)
4
Q

A
Trichomonas sp.
Tritrichomonas foetus
5
Q

A
Trichomonas gallinae (clinical signs)
6
Q

A
Histomonosis
Histology of Histomoniasis (PAS)
7
Q

A
Histomonosis (clinical signs)
8
Q

A
Histomonosis (histology)
9
Q

A
Histomonosis (pathology)
10
Q

A
Histomonosis (pathology)
11
Q

A
Giardia—cyst
12
Q

A
Giardia—cyst
13
Q

A
Giardia—cyst
14
Q

A
Giardia - trophozoite
15
Q

A
Giardia - trophozoite
16
Q

A
Giardia - trophozoite
17
Q

A
Giardia - trophozoite
18
Q

A
Entamobea - cyst
19
Q

A
Entamobea - cyst
20
Q

A
Leishmania - amastigote
21
Q

A
Leishmania - amastigote
22
Q

A
Leishmania - promastigotes
23
Q

A
Leishmaniosis in dog
24
Q

A
Eimeria acervulina coccidiosis
E. acervulina - histology
25

**Eimeria acervulina coccidiosis**
E. acervulina - histology
26

**Eimeria acervulina coccidiosis**
E. acervulina - histology
27

**E. acervulina** **(coccidiosis)**- pathology
28

**Eimeria maxima coccidiosis**
E. maxima – histology
29

**E. maxima (coccidiosis)** – pathology
30

**Eimeria tenella coccidiosis**
E. tenella – histology
31

**Eimeria tenella coccidiosis**
E. tenella – histology
32

**E. tenella (coccidia)** - pathology
33

**Eimeria brunetti coccidiosis** (pathology)
34

**Eimeria necatrix coccidiosis** (pathology)
35

**E. stiedai (coccidia)** – histology
36

**E. stiedai (coccidia)** – histology
37

**E. stiedai (coccidia)** – histology
38

**E. stiedai (coccidia)** – histology
39

**E. stiedai (coccidia)** – histology
40

**E. stiedai (coccidia)** – pathology
41

**E. stiedai (coccidia)** – pathology
42

**Eimeria intestinalis coccidiosis**
(pathology)
43

**Eimeria flavescens coccidiosis**
(pathology)
44

**E. truncata (coccidia)** – histology
45

**E. truncata (coccidia)** – pathology
46

**Eimeria anseris coccidiosis** (pathology)
47

**Eimeria coccidia**
**Globidium** (histology)
48

**Eimeria-oocysts**
A.Oocyst, B. Schizont, C. Oocyst, D. Globidium
49

**Sarcocystiosis** - histology
50

**Sarcocystiosis** - histology
51

**Sarcocystiosis** - histology
52

**Sarcocystiosis** - pathology
53

**Sarcocystiosis** - pathology
54

**Sarcocystiosis** - pathology
**S. tenella** (=ovicanis)
55

**Sarcocystiosis** - pathology
**S. gigantea** (=ovifelis)
56

**Sarcocystiosis** - pathology
57

**Cryptosporidium**-oocysts in smear
58

**Cryptosporidium**-oocysts in smear
59

**Cryptosporidium**-oocysts in smear
60

**Cryptosporidium**-oocysts in smear
61

**Toxoplasma gondii**
**T. gondii** - Tachyzoites
62

**Toxoplasma**
**T. gondii** - Tachyzoites
63

**Toxoplasma**
**T. gondii** - Cyst
64

**Toxoplasma**
**T. gondii** - Cyst
65

**Toxoplasma**
**T. gondii** - Cyst
Cysts are under low and high magnification
in the brain of an experimental animal
66

**Toxoplasma**
**T.gondii** - Sporolated oocyst
67
**Babesia sp.** in blood smear
68

**Babesia sp**. in blood smear
69

**Encephalitozoon cuniculi** – histology (spore)
70

**Encephalitozoon cuniculi** – histology (spore)
71

**Encephalitozoon cuniculi** – cliniclal signs
72

**Encephalitozoon cuniculi** – pathology


